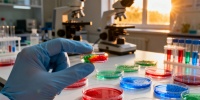
В России создают восемь съедобных вакцин против вирусов и грибков

Вирусолог Протасова заявила, что мнения о версии США по COVID-19 расходятся
Фото: Baltphoto
В Соединенных Штатах обнародовали данные о возникновении коронавируса, нанесшего значительный ущерб миру. В то же время российский специалист по вирусам выдвинул собственную версию этих событий.
В беседе с изданием RuNews24.ru доктор медицинских наук по специальности вирусология Светлана Протасова задалась вопросом, могли ли американцы создать квантовый вирус, способный одновременно находиться в двух местах.
Она отметила, что вирус, возможно, «поднаторел» в этом вопросе за тысячелетия эволюции, пока его моторные белки перемещали по микротрубочкам нейронов, где, по мнению некоторых ученых, происходят квантовые процессы и даже может находиться «квантовая душа» человека.
Вирусолог отметила, что исследования показали возможность заражения данным вирусом культур человеческих клеток и организмов животных, где он успешно существовал и размножался.
Она пояснила, что при проникновении в клетку вирус использовал чужеродные мышиные шиповидные белки как собственные, что способствовало его проникновению. По словам специалиста, такая адаптация, по-видимому, создала для вируса благоприятные условия и расширила возможности его распространения.
Эксперт отметила, что необычная устойчивость искусственно созданного вируса могла привлечь внимание специалистов по разработке биологического оружия, которые, вероятно, учли это в своих исследованиях. Она обратила внимание, что первые сведения о новом синтетическом коронавирусе были опубликованы еще в 2008 году в журнале PNAS, однако эти данные, по ее словам, замалчиваются.
Протасова пояснила, что данное исследование представляло собой длительную и трудоемкую работу, проведенную американскими, а не китайскими учеными, что подтверждается научными публикациями. Она отметила, что профессор Барик в своем докладе предупреждал о потенциальной возможности использования технологии синтеза вирусных последовательностей для создания биологического оружия массового поражения.
При этом эксперт подчеркнула, что в научных статьях 2008 и 2015 годов исследователи указывали на исключительно научные цели создания искусственных вирусов, отрицая какие-либо намерения по их применению в качестве биооружия.
Однако Протасова допустила, что заявление профессора Барика могло привлечь внимание лиц, заинтересованных в разработке биологического оружия.
 Кирилл Дмитриев предупредил о риске масштабного кризиса в Европе
Руководитель РФПИ сравнил текущую ситуацию с началом пандемии. Он считает, что Европа недооценивает угрозу. Дмитриев советует готовиться к серьезным переменам. Важную роль могут сыграть российские энергоресурсы....
Кирилл Дмитриев предупредил о риске масштабного кризиса в Европе
Руководитель РФПИ сравнил текущую ситуацию с началом пандемии. Он считает, что Европа недооценивает угрозу. Дмитриев советует готовиться к серьезным переменам. Важную роль могут сыграть российские энергоресурсы....  Семья сибирячки добилась компенсации после трагедии в больнице
Родные женщины из Новосибирской области выиграли суд. Им присудили компенсацию за некачественную медпомощь. Решение суда стало важным для семьи. Подробности истории вызвали широкий общественный резонанс....
Семья сибирячки добилась компенсации после трагедии в больнице
Родные женщины из Новосибирской области выиграли суд. Им присудили компенсацию за некачественную медпомощь. Решение суда стало важным для семьи. Подробности истории вызвали широкий общественный резонанс....  В Петербурге за неделю резко снизилось число случаев COVID-19 и ОРВИ
В Петербурге зафиксировано заметное снижение сезонных инфекций. Специалисты отмечают спад заболеваемости COVID-19 и ОРВИ. Жителям напоминают о мерах профилактики...
В Петербурге за неделю резко снизилось число случаев COVID-19 и ОРВИ
В Петербурге зафиксировано заметное снижение сезонных инфекций. Специалисты отмечают спад заболеваемости COVID-19 и ОРВИ. Жителям напоминают о мерах профилактики...  Генетики раскрыли, почему пандемии чаще всего не связаны с лабораториями
Новое исследование меняет взгляд на происхождение пандемий. Ученые анализируют геномы вирусов. Один случай выделяется на фоне остальных. Подробности - в нашем материале....
Генетики раскрыли, почему пандемии чаще всего не связаны с лабораториями
Новое исследование меняет взгляд на происхождение пандемий. Ученые анализируют геномы вирусов. Один случай выделяется на фоне остальных. Подробности - в нашем материале.... В России создают восемь съедобных вакцин против вирусов и грибков
В Институте экспериментальной медицины ведется работа над инновационными вакцинами. Ученые используют пробиотики для защиты от вирусов и грибков. Проект стартовал во время пандемии. Ожидаются новые подходы к профилактике заболеваний....
В России создают восемь съедобных вакцин против вирусов и грибков
В Институте экспериментальной медицины ведется работа над инновационными вакцинами. Ученые используют пробиотики для защиты от вирусов и грибков. Проект стартовал во время пандемии. Ожидаются новые подходы к профилактике заболеваний....  В Петербурге зафиксировано снижение заболеваемости ОРВИ на 14 процентов
В Петербурге отмечено снижение числа заболевших ОРВИ. Эпидемические пороги не превышены. В Ленобласти ситуация стабильна. Власти продолжают следить за динамикой....
В Петербурге зафиксировано снижение заболеваемости ОРВИ на 14 процентов
В Петербурге отмечено снижение числа заболевших ОРВИ. Эпидемические пороги не превышены. В Ленобласти ситуация стабильна. Власти продолжают следить за динамикой....  Ученые раскрыли, почему после COVID-19 вкус может не возвращаться месяцами
Исследователи нашли новые причины долгой потери вкуса после COVID-19. Открытие может изменить метод к лечению. Врачи объяснили, почему вкус не всегда возвращается быстро. Подробности - в нашем материале....
Ученые раскрыли, почему после COVID-19 вкус может не возвращаться месяцами
Исследователи нашли новые причины долгой потери вкуса после COVID-19. Открытие может изменить метод к лечению. Врачи объяснили, почему вкус не всегда возвращается быстро. Подробности - в нашем материале....  В Петербурге врача осудили условно за фиктивные COVID-сертификаты
Врач из Петербурга оказалась на скамье подсудимых. Ее обвинили в продаже фиктивных сертификатов. Суд вынес условный приговор. История вызвала широкий общественный резонанс....
В Петербурге врача осудили условно за фиктивные COVID-сертификаты
Врач из Петербурга оказалась на скамье подсудимых. Ее обвинили в продаже фиктивных сертификатов. Суд вынес условный приговор. История вызвала широкий общественный резонанс.... _0.jpg) Петербургская врач инсценировала болезнь ради выплат на 300 тысяч рублей
Врач из Петербурга оказалась в центре уголовного дела. Она оформила фиктивную справку о болезни. Сумма выплат составила 300 тысяч рублей. Следствие продолжается....
Петербургская врач инсценировала болезнь ради выплат на 300 тысяч рублей
Врач из Петербурга оказалась в центре уголовного дела. Она оформила фиктивную справку о болезни. Сумма выплат составила 300 тысяч рублей. Следствие продолжается.... Рекомендовано Петербургом 2
|
Как пережить отключение горячей воды в Петербурге
Топ-события Петербурга на этой неделе: Дмитрий Маликов, Settlers и гала-концерт в честь Майи Плисецкой
Топ-события Петербурга на этой неделе: «Олдтаймер-Галерея», «Ундервуд» и Сергей Бобунец
От телескопа до шавермы под Луной: космические места Петербурга
В Музее Фаберже открылась выставка о транспорте в искусстве
Как провести время в Петербурге при сбоях мобильного интернета












